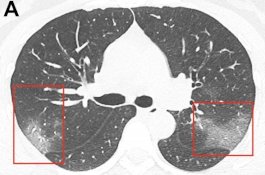
Foto X-Ray Menunjukkan Efek Mengerikan Coronavirus pada Paru-paru Pasien

Berita/Artikel
Banding Ditolak, 'Monster' yang Penggal Kepala Bayi Akan Dieksekusi oleh Regu Tembak
News
- 03 Februari 2020 08:29
Anjing Mengendus Dada Pemiliknya Selama 2 Bulan, Rupanya Deteksi Kanker
Health
- 02 Februari 2020 19:59
Khabib Nurmagomedov Ditawari Rp1,3 Triliun untuk Lawan Floyd Mayweather di Saudi
Sports
- 02 Februari 2020 19:32
Tiga Budak Dikunci di Pertanian Ganja Rahasia, Hanya Diberi Sedikit Nasi
News
- 02 Februari 2020 19:02
Berebut 'Minyak Diberkati', 20 Orang Tewas Dalam Kebaktian Gereja di Tanzania
News
- 02 Februari 2020 17:59
"Tolong Ambil Putriku," Ibu Memohon ke Polisi, Putrinya Perlu Jalani Kemoterapi di Luar Hubei
News
- 02 Februari 2020 17:26
Nenek 80 Tahun Memohon Pada PM Inggris Agar Diizinkan Nikahi Brondongnya dari Mesir
News
- 02 Februari 2020 14:01
Kerja Siang Malam, 2 Dokter Malah Dipukuli Keluarga Pasien Corona yang Meninggal
News
- 02 Februari 2020 13:23
Filipina Laporkan Kematian Akibat Virus Corona, Pertama di Luar China
News
- 02 Februari 2020 12:23
Pembantu Asal Indonesia Dijual Sebagai Pelacur Seharga Rp13 Juta di Dubai
News
- 02 Februari 2020 10:36
Foto X-Ray Menunjukkan Efek Mengerikan Coronavirus pada Paru-paru Pasien
Health
- 02 Februari 2020 08:59
Suami Penggal Istrinya, Lalu Menenteng Kepalanya Sambil Berjalan Lebih 1 Km
News
- 02 Februari 2020 08:27
"Mohon Singkirkan Pria ini!" Istri Gugat Cerai Suami Karena Jarang Mandi
News
- 01 Februari 2020 18:59
Uang Rp289 Ribu Menjadi Penyebab Putra Mantan Tentara Habisi Orang Tuanya
News
- 01 Februari 2020 17:24
Pria yang Pernah Beri Makan Serigala Hilang Misterius, Diduga Telah Dimangsa
News
- 01 Februari 2020 12:55
Hendak Dijual Rp30 Miliar, Al-Quran Tulisan Emas Diselamatkan dari Pencuri
News
- 01 Februari 2020 12:29
Populer